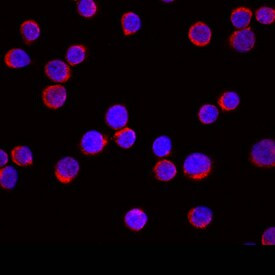
EMP Antibody in Immunocytochemistry (ICC/IF)

Search
Invitrogen
EMP Polyclonal Antibody
{{$productOrderCtrl.translations['antibody.pdp.commerceCard.promotion.promotions']}}
{{$productOrderCtrl.translations['antibody.pdp.commerceCard.promotion.viewpromo']}}
{{$productOrderCtrl.translations['antibody.pdp.commerceCard.promotion.promocode']}}: {{promo.promoCode}} {{promo.promoTitle}} {{promo.promoDescription}}. {{$productOrderCtrl.translations['antibody.pdp.commerceCard.promotion.learnmore']}}
图: 1 / 4
EMP Antibody (PA5-47914) in ICC/IF




产品信息
PA5-47914
种属反应
已发表种属
宿主/亚型
分类
类型
抗原
偶联物
形式
浓度
规格
纯化类型
保存液
内含物
保存条件
运输条件
RRID
产品详细信息
Reconstitute in sterile PBS to a final concentration of 0.2 mg/mL.
靶标信息
This gene product mediates the attachment of erythroblasts to macrophages. This attachment promotes terminal maturation and enucleation of erythroblasts, presumably by suppressing apoptosis. This protein is an integral membrane protein with the N-terminus on the extracellular side and the C-terminus on the cytoplasmic side of the cell. Two immunologically related isoforms of erythroblast macrophage protein with apparent molecular weights of 33 kD and 36 kD were detected in macrophage membranes, this gene encodes the larger isoform. Multiple alternatively spliced transcript variants encoding distinct isoforms have been found for this gene, but the biological validity of some variants has not been determined.
仅用于科研。不用于诊断过程。未经明确授权不得转售。
生物信息学
蛋白别名: Cell proliferation-inducing gene 5 protein; E3 ubiquitin-protein transferase MAEA; Erythroblast macrophage protein; GID complex subunit 9, FYV10 homolog; HLC-10; Human lung cancer oncogene 10 protein; lung cancer-related protein 10; Macrophage erythroblast attacher; P44EMLP; PIG5; unnamed protein product
基因别名: 1110030D19Rik; EMLP; EMP; GID9; HLC-10; HLC10; MAEA; P44EMLP; PIG5
UniProt ID: (Human) Q7L5Y9, (Rat) Q5RKJ1, (Mouse) Q4VC33
Entrez Gene ID: (Human) 10296, (Rat) 298982, (Mouse) 59003